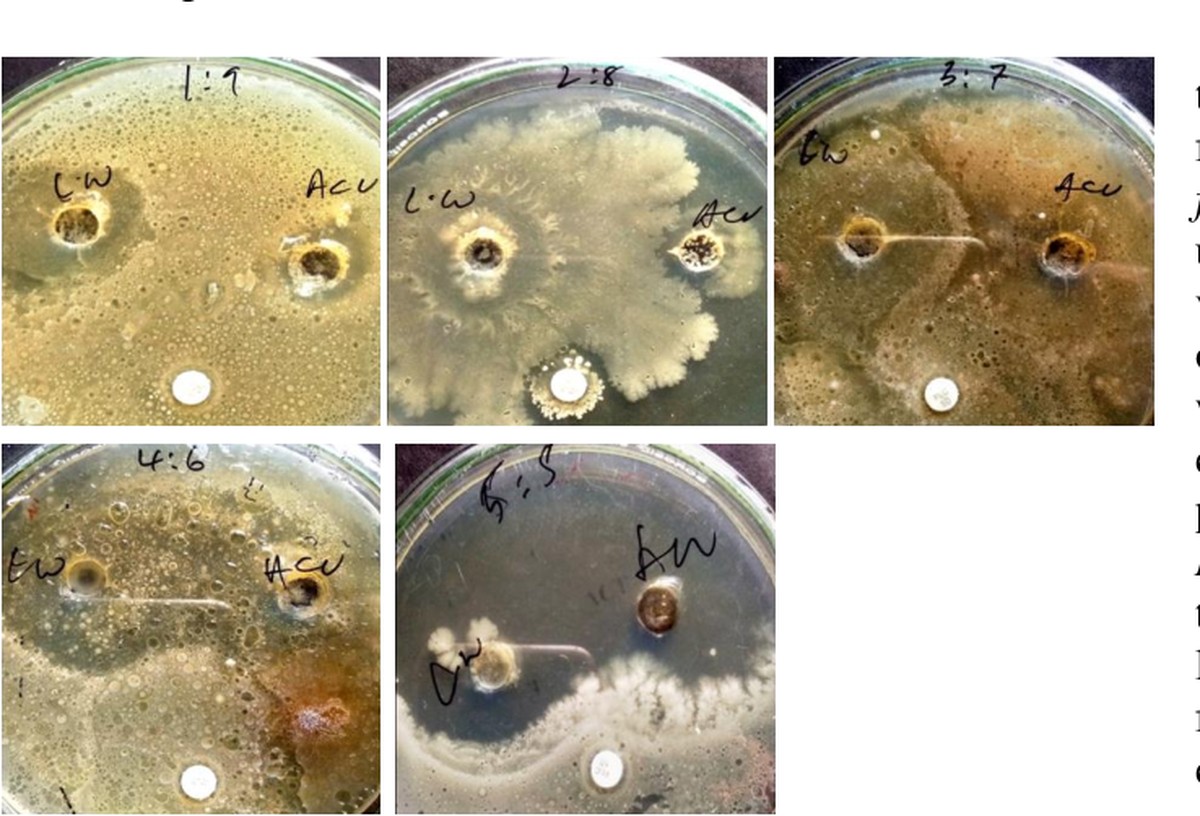
Citrónová šťáva na listech rajčat: co vědí biologové, a skrývají to - image 2

Zaléváte rajčata, postříkáte je citronem a doufáte, že zlikvidujete choroby? Mnoho zahrádkářů v Česku to zkouší — a pak se diví spáleným listům nebo nulovému efektu. Teď je důležité vědět, co funguje, co je nebezpečné, a proč některé rady z facebookových skupin mohou vaše rostliny zničit.
V mé praxi jsem viděl všechno: od slepých pokusů s čerstvou citronovou šťávou po rozumné, bezpečné testy, které dávají výsledky. Čtěte dál, protože tady je to, co jsem si opravdu všiml — a co byste měli zkusit sami.
Proč lidi sahají po citronu na listech
Lidé v Česku sahají po citronu z několika důvodů: je levný (citrón za 10–30 Kč v Lidlu nebo Kauflandu), dostupný a má pověst „přírodního“ léčiva. Navíc v létě, kdy slunce praží a pohled na napadené listy bolí, hledáme rychlé řešení.
- Je to kyselina — lidé věří, že kyselina zabije plísně a bakterie.
- Je to domácí prostředek, nikdo nemusí jít do Hornbachu pro chemii.
- Mnozí to doporučí v komunitách, protože „to pomohlo mně“.
Co biologové opravdu vědí (krátké a ostré)
Biologická realita je méně romantická než fotky „před a po“ na Instagramu. Citronová šťáva není univerzální lék — v Petriho misce může citrát omezit růst některých kvasinek nebo bakterií, ale na rostlinných listech to funguje jinak.

- Citric acid má silnou kyselost (pH kolem 2) — to může poškodit rostlinné buňky.
- V laboratorních podmínkách je účinná proti některým patogenům, ale pole je špinavé a slunce mění reakci.
- Citron nezlikviduje systémové nemoci; působí jen povrchově.
Co vás může překvapit
Všiml jsem si dvou opakujících se chyb: lidé aplikují koncentrát na sluncem rozžhavené listy, nebo dělají aplikace příliš často. To vede k popáleninám listů — listy žloutnou a odumírají rychleji než původní nemoc.
Nikdy neaplikujte koncentrovanou šťávu v poledním slunci. To je krátká rada, která zachrání mnoho rostlin v horkých červencových dnech v Česku.
Mýty versus fakta — rychlý přehled
- Mýtus: „Citron zničí plíseň úplně.“ — Fakt: Může zpomalit růst některých spór povrchově, ale často nestačí.
- Mýtus: „Přírodní = bezpečné.“ — Fakt: Přírodní kyselina může listy spálit.
- Mýtus: „Vyrobíte z vody a citronu dokonalý postřik.“ — Fakt: Správné ředění a test jsou klíčové.
Jak to bezpečně vyzkoušet: krok za krokem (životní hack)
Tahle metoda mi zachránila sezónu víc než jednou — jednoduchá, levná a bezpečná pro balkón i zahradu u rodinného domu v Česku.
- Potřebujete: 1 čerstvý citrón (10–30 Kč), čistou vodu, 10ml stříkačku nebo odměrku, rozprašovač (zakoupíte v zahradnictví nebo OBI).
- Ředění: Smíchejte 1 díl citronové šťávy s 10–20 díly vody (např. 10 ml šťávy + 150–200 ml vody).
- Test: Nastříkejte na jednu spodní část listu odpoledne, ne na slunci. Po 48 hodinách zkontrolujte reakci.
- Aplikace: Pokud není žádné spálení, aplikujte večer, maximálně 1× týdně a vždy po dešti počkejte do večera.
- Alternativa: Přidejte pár kapek slabého mýdla (ne agresivního odmašťovače) jako smáčedlo — pomůže šťávě zůstat na listu, ale opět testujte.
Praktické tipy, které málokdo zmíní
- Testujte na nejnižším listu — ten snese nejméně poškození.
- V deštivém období v Česku je riziko, že opláchnete účinek do půl hodiny.
- Pokud máte bio pěstování: informujte se v místním Zahrádkářském svazu, některé praktiky mohou ovlivnit certifikaci.
Nebezpečí, které ignorujeme
Viděl jsem zahrádky, kde lidé používají citron týdny — listy zhnědnou, sklizeň se zmenší. To není „nepodařená sezóna“, to je chemické zranění. A navíc: citrón mění pH listu, což může povzbudit jiné patogeny.
By the way, v českém podnebí — s častými lijáky na jaře a horkými letními dny — je reakce rostlin na kyseliny ještě nepředvídatelnější.
Co dělat místo slepého kopírování rad
- Zaměřte se na prevenci: střídání odrůd, správné hnojení, větrání skleníku.
- Používejte certifikované agrotechnické prostředky, pokud chcete spolehlivost (koupíte v Hornbachu, OBI nebo specializovaných e-shopech).
- Testujte vše na malém vzorku rostliny — to ušetří čas i peníze.
Všiml jsem si, že ti, kdo mají největší úspěch, kombinují rozumné domácí triky s ověřenou péčí. Citron může být nástroj — ale ne náhradou za rozumnou agronomii.
Krátké shrnutí
Citronová šťáva může povrchově potlačit některé organismy, ale často zároveň spálí listy a neposkytne dlouhodobou ochranu. Pokud to chcete zkusit, ředění, testování a večerní aplikace jsou klíč. Mnozí poradci na sítích tuhle elementární opatrnost vynechávají — já jsem to viděl na vlastní oči.
Co Vy myslíte — zkusili jste někdy citron na listech rajčat a jak to dopadlo? Napište níže své zkušenosti a tipy, ať se ostatní poučí z vašich chyb i úspěchů.
